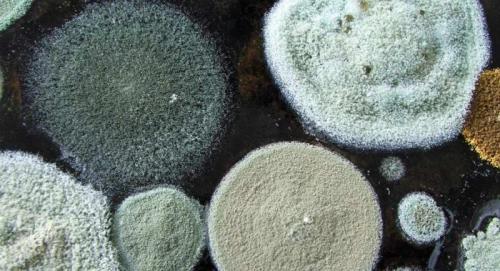
Плесень в подвале деревянного дома, как избавиться. Грибок в подвале частного дома: как избавиться от упрямой плесени?

Плесень в углах дома. Как устранить причину возникновения плесени
- Плесень в углах дома. Как устранить причину возникновения плесени
- Как удалить грибок и плесень на стенах навсегда самостоятельно. Средства (современные и народные), призванные удалить грибок со стен
- Плесень под обоями, как избавиться в домашних условиях. Плесень под обоями, как избавиться
- Лучшее средство от черной плесени. Специализированные средства
- Белая плесень на земле комнатных растений, как избавиться. Методы борьбы с плесенью
- Плесень в подвале деревянного дома, как избавиться. Грибок в подвале частного дома: как избавиться от упрямой плесени?
- Плесень в углах дома причина. Причины возникновения плесени в подвале и цоколе частного дома
- Видео почему появляется грибок и плесень в углах. Заделка панельных швов. Как заделать панельный шов.
Плесень в углах дома. Как устранить причину возникновения плесени
При обнаружении у себя дома черного налета нужно немедленно принимать меры. Причем удаление только верхнего слоя грибка будет неэффективным. Мицелий паразита проникает глубоко в материал, и если снять только верхний слой, то проблема быстро вернется.
Выбор варианта борьбы зависит от размеров повреждения: если очаг небольшой, то можно попробовать справиться с ним самостоятельно с помощью народных или покупных средств. Если же площадь поражения большая, то лучше всего обратиться за помощью в профессиональную организацию.
Прежде всего специалисты проведут лабораторный анализ поселившейся у вас плесени и выявят, к какому виду она относится. От этого зависит способ, которым правильнее всего ее убить.

Затем начнется работа мастеров по очищению жилья. Здесь применяются профессиональные инструменты, химикаты, тепловые пушки. Как правило, процесс занимает не один день, поэтому на этот период жильцам хорошо бы покинуть квартиру и пожить у родственников.
Какой бы вариант вы ни выбрали, знайте – без устранения источника возникновения все это бесполезно: напасть вернется и вновь атакует.
Чтобы вывести нежеланного гостя, необходимо предпринять следующие действия:
- ликвидировать протечки на крыше и в подвале;
- проверить целостность межпанельных швов – особенно это актуально, если плесень растет в углу комнаты панельного дома;
- утеплить квартиру – это поможет, когда в квартире холодно. Правильно будет утепляющий слой и облицовку располагать с наружной стороны здания;
- наладить вентиляцию – при плохом функционировании вытяжки требуется прочистить ее. Хорошим решением будет установка дополнительного вентилятора. Также нелишне поставить вытяжку над плитой, чтобы удалять испарения от готовящейся пищи;
- обеспечить достаточный воздухообмен – для этого лучше установить приточные клапаны на пластиковые окна и минимум дважды в день проветривать помещение в любое время года;
- уменьшить влажность в комнате – для этого придется отказаться от сушки белья в квартире и убрать комнатные растения.
Как удалить грибок и плесень на стенах навсегда самостоятельно. Средства (современные и народные), призванные удалить грибок со стен
- Один из лидеров средств, действие которых направлено против плесени на стенах – грунтовка-антисептик. Она не только избавляет дом от плесени, но и препятствует ее повторному появлению. Также преимуществом является простота в использовании, обычно ее не нужно разводить водой, и в инструкции подробно описано, как наносить грунтовку. Основное правило таково: сначала необходимо полностью очистить поверхность стены от грибка (хорошо для этих целей использовать скребок или шпатель), затем на высушенную поверхность кистью нанести грунтовку-антисептик. После ее высыхания можно завершать работу, покрывая стену обоями или краской.
- Отлично справляется с плесенью на стене обычный отбеливатель (гипохлорит натрия), способный уничтожить плесневый грибок вместе со спорами. Хорошо получается удалять им плесень на стенах в ванной и таких стенах в комнатах, которые не страшно случайно обесцветить. Однако препарат совсем небезопасен, поэтому при использовании стоит задуматься о защите кожи рук, тела, а также озаботиться проветриванием помещения. Обычно делают раствор (1:10).

- Уксусом обрабатывают поврежденные плесенью участки, используя для этого распылитель или влажную тряпочку, после чего, спустя час, смывают и проветривают комнату. Для закрепления результата повторяют процедуру каждую неделю, распыляя небольшое количество уксуса. Действие его против грибка обусловлено тем, что это кислота, а потому он способен устранять плесень, при этом не нанося вреда здоровью человека, т. к. совершенно нетоксичен.
- Перекись водорода – также отличное средство (антибактериальное и противогрибковое), помогающее избавиться от плесневого грибка: 3% раствор препарата не только уничтожает многие виды плесени, но и отбеливает поверхность стены (не используйте на стенах, покрытых краской).
- Если грибок поразил стены из непористых материалов (например, плитку), тогда вам может помочь избавиться от напасти Нашатырный спирт. Раствор нашатыря (соотношение с водой 1:1) наносят на пораженный участок с помощью распылителя и через несколько часов смывают. Главный недостаток метода – сильный запах, в некоторых случаях вызывающий головную боль или боль в горле. Используйте респиратор.
- Как средство против грибка популярна и обычная сода, имеющая репутацию совершенно безопасного очистителя в хозяйстве. Поэтому при использовании ее в качестве противогрибкового средства вы можете совершенно не волноваться о вреде здоровью. Раствор изготавливают так: 1 ч. л. соды на 1 ст. воды. Его наливают в пульверизатор и опрыскивают им участки стен, пораженные плесенью. Для достижения наилучшего результата смывать соду не надо.

- Фунгицидный раствор – зарекомендовавшее себя средство, эффективно борющееся с проблемой грибка на стенах. Им нужно обработать зачищенную от плесени поверхность, а затем, через 5-6 ч. повторить процедуру. Для получения наилучшего результата рекомендуют обрабатывать стены таким образом 4-5 раз, после чего следует нанести грунтовку-антисептик.
- Также способна справиться с грибком и совершенно безопасная для здоровья человека бура, являющаяся при этом токсином для плесени. Необходимо наносить раствор буры (1 ст. средства на 2,5 л воды) непосредственно на плесневый грибок с помощью грубой щетки, при этом механически счищая плесень со стены. Обрабатывают раствором стену неоднократно, при этом не смывая средство водой, с целью профилактики.
- Эфирное масло чайного дерева является популярным народным средством в деле избавления дома от грибка благодаря натуральному противогрибковому и антибактериальному эффекту. Несмотря на высокую цену, его потребуется совсем чуть-чуть (1 ч. л. на 1 ст. воды). В использовании средство является совершенно простым, нужно лишь нанести его на поврежденный плесенью участок стены с помощью губки или пульверизатора, при этом смывать ничего не нужно. Если раствор останется, его можно спокойно использовать спустя время, т. к. масло чайного дерева не теряет своих свойств.

- Также с грибком справится и экстракт грейпфрутовых косточек — природный антисептик. Его используют из расчета 10 капель на 1 ст. воды. Обрабатываем стену с плесенью таким же образом, как и при использовании масла чайного дерева, раствор не смываем для наилучшего эффекта. Преимуществом средства является то, что оно не имеет запаха, при этом отлично дезинфицирует и дезодорирует поверхность.
- Раствор марганцовки (1 ч. л. на 1 л воды) тоже способен помочь в борьбе с грибком на стенах. Пользоваться им так же легко, как и другими народными средствами: необходимо лишь нанести раствор на участок поврежденной стены с помощью губки или пульверизатора, не смывая.
- Раствор воды со смесью перекиси, уксуса и Борной кислоты (соотношение 4:2:2:1) способен дать отличный эффект, с легкостью очистив ваши стены от надоевшего грибка. Это простое, но вместе с тем очень эффективное средство, использовать которое очень легко: его можно либо распылить, либо нанести с помощью тряпки на стену, пораженную плесенью.
Плесень под обоями, как избавиться в домашних условиях. Плесень под обоями, как избавиться
Плесень под обоями на стене, как избавиться? Каждый человек в своей жизни хотя бы раз да сталкивался с такой серьезной проблемой, как плесень. Она может появиться где угодно и на разных поверхностях. Обычно плесень появляется в плохо проветриваемых и сырых помещениях. Любые грибковые образования плохо влияют на общее состояние всех живущих в доме жильцов. Настоящим бедствием для жильцов становится появление плесени. Такое присутствие может испортить самый дорогостоящий.

Любые грибковые образования губительно влияют на здоровье всех проживающих. Особенно в зоне риска находятся дети, а также члены семьи преклонного возраста. В этой статье речь пойдет о том, как можно быстро избавиться от неприятного запаха в своем жилье и навсегда удалить плесень.
Что такое плесень
Это грибок (растение). Заметный темный налет, который может образоваться в любом теплом и сыром месте. Размножение происходит с помощью спор. (Средства от плесени можно приобрести, огромный выбор).

Споры — это семена, которые находятся в покое, если не попадают в питательную среду. Они разносятся потоком воздуха, поэтому могут проникать в любые труднодоступные места. Даже внутрь различных поверхностей, поэтому плесень вывести зачастую нелегко.
Причины появления грибка;
- отопление в помещении неравномерное;
- климатические условия. Температура воздуха выше 20 градусов при влажности 70-90%;
- плохая вентиляция в помещении.
Первые признаки плесени?
При появлении резкого специфического запаха, следует незамедлительно провести комплекс мероприятий по обнаружению и полному уничтожению опасного соседства.
Что нужно приготовить для успешной борьбы? 
Перед тем как приступить к обработке обязательно приготовьте;
- резиновые перчатки;
- очки;
- респиратор;
- специальную одежду для собственной защиты от вещества, которым обрабатывается поверхность.
Для борьбы с плесенью используются разные способы. Это могут быть бытовые (народные) методы или более эффективные химические препараты, которые продаются в магазинах.
Для технического удаления понадобится;
- щеточка, губка, тряпка, наждачная бумага, скребок;
- емкость для воды, чистящее или моющее средство, пакет под мусор.
Для окончательной обработки применим средство, уничтожающее споры. И удаляем плесень раз и навсегда.
Плесень под обоями: методы борьбы

Для эффективного результата следует произвести следующий порядок действий:
- Техническая очистка от плесени пораженного участка.
- Обработка бытовыми или химическими средствами захватывая большую площадь.
- Хорошо просушить те участки, которые подвергались обработке.
- Проветрить все помещение.
Полезные советы
Важно! В благоприятных условиях плесень разрастается очень быстро и может повлечь за собой массу неприятностей. Начиная от нехорошего вида и неприятного запаха. Заканчивая различными хроническими заболеваниями всех членов семьи. Поэтому незамедлительно приступайте к ликвидации опасного растения пока он не проник сквозь штукатурку и бетон
Чтобы грибок не распространился дальше, сразу убирайте мусор в герметичный пакет.
Какое средство от грибка выбрать?

Под обоями плесень как избавиться? Самые распространенные средства, которые найдутся в доме это;
- соль для деревянных поверхностей;
- отбеливатель — очищает кафельную плитку и стекло. Не подойдет для пористых материалов. Имеет сильный запах(токсичен), поэтому нужно разводить водой 1/10,
- нашатырный спирт;
- перекись водорода — удобное и безопасное средство. Наносится на любые поверхности. Не наносить на мебель и обои, так как может поменяться цвет;
- уксус — хорошо наносится на все материалы, имеет резкий запах. Не рекомендуется опрыскивать мебель и обои, так как может повлиять на цвет;
- лимонная кислота. Имеет ароматный запах, хорошо обрабатывает любые поверхности, хорошо очищает плитку (1 ст ложку лимонной кислоты размешать в 1 стакане воды);
Как избавиться от запаха плесени
Чтобы избавиться от запаха плесени, нам понадобится;
- засыпать тонким слоем пищевую соду на то место, где рос грибок. Оставить на 3-4 часа. Затем лучше всего смести или собрать пылесосом;
- древесный уголь. Разложить емкости с углем по периметру комнаты. Через несколько дней запах сырости исчезнет.
Лучшее средство от черной плесени. Специализированные средства
В магазинах можно найти целый класс антисептиков, способных успешно бороться с любыми видами плесневелых грибов. Они стоят дороже уксуса или перекиси, но пользы от них больше. У каждого – своя специфика применения.
Так, например, «Биотол-спрей» часто используется там, где постоянно присутствует высокий порог влажности. Он идеально подходит для профилактической обработки прачечных, ванных комнат, крытых бассейнов. Им обрабатывают службы коммунального хозяйства уличные объекты (заборы, памятники). Чуть-чуть уступает этому средству по мощности препарат под названием «Олимп стоп-плесень». Это лучший препарат от плесени на стенах подвалов, погребов, других помещений, где сыро и нет дневного света. Профилактическая обработка позволяет предотвратить поражение. Им можно проводить и «лечение» уже годами формирующегося процесса.
Специально для борьбы с черной плесенью был разработан препарат «Фонгифлюид Альпа». Это фунгицид нового поколения. Когда плесень была успешно устранена, еще какое-то время нужно обрабатывать стены для профилактики повторного поражения. Для этого лучше использовать жидкое средство «Дали».
Правила проведения химической обработки
Выбирая метод борьбы, важно помнить о том, что любое из перечисленных средств в чистом виде способно повредить здоровью человека. Поэтому перед работой нужно обезопасить себя: надеть на руки перчатки, закрыть лицо респиратором или маской. Правила использования препарата детально описаны производителем в инструкции. В процессе применения важно следовать им. В техническом паспорте состава указана дозировка, способная уничтожить грибок. Экспериментировать с ее изменением нельзя.
Обычно перед работой средство разбавляется с водой, затем наносится на пораженный участок. Для работы может понадобиться строительный шпатель, жесткая щетка, валик или распылитель. Перед нанесением препарата место нужно расчистить: снять покрытие. Грибок поражает сначала верхние слои, он особенно быстро распространяется внутри стен, покрытых штукатуркой. Ее он насквозь пронизывает и формирует разветвленную грибницу. Поэтому сначала шпателем нужно убрать полностью материал покрытия, и только потом начинать «травить» грибок. Обычно средство от плесени на стенах оставляется до тех пор, пока оно само не высохнет.
Какую выбрать краску для фасада деревянного дома – полезные советы
Если с первого раза не удалось устранить проблему, придется произвести повторную обработку. После того, как основа тщательно просохнет, ее нужно покрыть антисептической грунтовкой и заново отштукатурить цементным раствором, после этого поверхность покрыть гидроизоляционным составом. Тогда удастся предотвратить возникновение «рецидивов». Правильно подобранная краска от плесени на стенах будет смотреться хорошо. Ее слой защитит от проникновения влаги и не позволит спорам гриба снова проникнуть вглубь отделки.
Когда поражены обои, наклеенные на бетонное основание, нужно полностью их снимать, тщательно шпателем счищать черный налет, и только потом обрабатывать участок антисептиками. Лучше всего для этого использовать составы глубокого проникновения. Они впитываются в пористую структуру бетона, убивают грибок и приостанавливают его распространение. Приступать к косметическому ремонту можно только когда антисептик полностью высохнет.
Зараженную плесенью обшивку из гипсокартона придется тоже полностью демонтировать и выбрасывать на улицу. Важно после демонтажа тщательно обследовать обрешетку. Отсутствие следов ее поражения не позволяет отказываться от профилактической дезинфекции. Это более актуально тогда, когда обрешетка собирается из дерева. Если тщательно пропитать все планки антисептиком для древесины, можно заново смонтировать гипсокартон.
Белая плесень на земле комнатных растений, как избавиться. Методы борьбы с плесенью
Если появилась плесень в земле и пахнет гнилью, то необходимо скорректировать график полива растения. Рекомендуется снизить частоту поливов и уменьшить объемы жидкости . Некоторым растениям достаточно иметь влажный грунт. В противном случае корни могут начать гнить, что приведет к грибковым инфекциям.
При обильном, но редком поливе необходимо систематически рыхлить грунт. Причем затрагиваться должны глубокие слои. Но следует быть осторожными, так как можно повредить корневой системе .
Как избавиться от плесени в цветочных горшках, не навредив растению:
- При обнаружении грибка необходимо убрать наружный слой грунта из цветочного горшка . Если этого не сделать, то инфекционный грибок начнет распространяться на внутренние слои, что приведет к гниению и гибели цветка.
- Далее необходимо увлажнить нижние слои почвы . Для этого в горшок выливается стакан воды с разбавленной в ней лимонной кислотой. Кислотная среда не дает грибку размножаться, что благоприятно сказывается на росте цветка.
- Следует заменить удаленный слой новым грунтом . В него необходимо добавить бактерицидные средства, которые также будут выступать в роли фильтрующих компонентов для поступающей влаги. Рекомендуется использовать такие добавки как измельченный сфагнум и древесные кусочки угля.
- Далее земля поливается специальным составом из фундазола : 2 грамма средства необходимо развести в 1 литре воды. При распространении инфекции на само растение, его также следует обработать раствором.
Чтобы обработка почвы имела эффективный результат, периодически требуется взрыхлять ее верхний слой. Это приведет к равномерному распределению влаги и предотвратит ее застой.
Если земля в горшке покрылась белой плесенью, то необходимо поливать растение раствором из воды с лимонной кислотой с периодичностью не менее 2-х раз в месяц. На 1 стакан жидкости берется 0,5 чайной ложки кислоты.
Пересадка растения
Если появилась плесень в цветочном горшке, как избавиться от нее быстро и эффективно? Действенным способом устранения грибковой инфекции является пересадка растения в новый горшок с полной заменой почвы. Грунт следует подбирать с учетом всех правил при посадке. Для определенных растений необходимо заранее выяснить оптимальную влажность.
Обеззараживание почвы
Для избавления от инфекции и запаха плесени можно произвести дезинфекцию почвы согласно инструкции:
- Разделить зараженный грунт от корней растения.
- Удалить землю из цветочного горшка и переложить ее в другую тару.
- Поставить кипятиться воду.
- Обдать грунт кипятком.
- Поместить землю на противень и прокалить в духовом шкафу.
- Выждать время, пока субстрат остынет .
- Обработать горшок специальным дезинфицирующим средством. Также можно произвести обжиг кашпо открытым огнем.
- Вернуть грунт в горшок, и посадить цветок.
Покупные средства
Избавиться от плесени можно при помощи химических средств. Их можно приобрести в цветочных магазинах.
Но выбирая такой метод, следует учитывать:
- вид грунта;
- особенности растения;
- степень распространения грибка;
- какие удобрения использовались для обработки почвы.
Применив неподходящее средство можно получить обратный эффект . А иногда применять химические реагенты для ликвидации плесневелых пятен нельзя.
Преимущество стоит отдавать органическим препаратам, которые влияют на грунт, и делают его неблагоприятным для развития грибка.
Плесень в подвале деревянного дома, как избавиться. Грибок в подвале частного дома: как избавиться от упрямой плесени?
10 мин.
Владельцы собственного жилья знают, что их здание — их крепость, в ней уютно, комфортно и безопасно. Однако не у всех и не всегда получается защитить дом от различных «захватчиков». Нежданные визитеры появляются в помещениях вопреки желанию жильцов, а избавиться от них бывает крайне трудно. Речь идет о живой угрозе, которая неустанно ищет свой «райский уголок», и зачастую находит его. Плесневый грибок в подвале частного дома — проблема, с которой приходится сталкиваться многим хозяевам. Появляются эти микроорганизмы незаметно, но после образования большой колонии вывести их становится почти невозможно. Чтобы освободиться от «напасти», надо узнать эффективные способы борьбы с грибком, а затем начать действовать — целенаправленно и безжалостно.
Что такое плесень?
Вряд ли об этом задумываются люди, пока они не обнаруживают, что их жилье, оказывается, колонизировали. Грибок в подвале частного дома — веская причина для начала «военных действий». Плесень — это споры, они невидимы, но присутствуют в воздухе практически везде. Если они находят идеальные условия для жизни, то быстро заселяются, затем начинают активно размножаться, поэтому вскоре их появление хозяева все-таки обнаруживают.
Виды плесневых грибков
Чтобы познакомиться с живой угрозой, а затем суметь от нее избавиться, сначала надо узнать, какие виды ее существуют.
Голубая

Эта «симпатичная» разновидность грибка не часто «посещает» жилые помещения. Ее «родной дом» — растущие деревья. Первый признак — голубовато-синеватый налет на древесине. Эта плесень практически безопасна для человека. Главное доказательство отсутствия угрозы — производство элитных сыров, в нем «голубые» споры принимают активное участие.

Плесень в углах дома причина. Причины возникновения плесени в подвале и цоколе частного дома
Влага является ключевым фактором, приводящим к возникновению и распространению плесени в подвальных помещениях и домах, однако это не единственно возможная причина.
Основные причины роста плесени в цоколе, подвале и погребе:
- Избыток влаги: Отсутствие качественно выполненной гидроизоляции плиты и стен подвала с внешней стороны приводят к тому, что материал, из которого они сделаны, будь то бетон, кирпич, блоки ФБС или другие виды блоков, напитывает воду как губка, становиться влажным и отдаёт эту влагу внутрь подвального помещения. Эта постоянная влага стен или фундамента как раз и приводит к возникновению разных грибков и споров.
При отсутствии или при нарушенной гидроизоляции вода и влага проникает в бетон или кирпич, зимой замерзает, а весной оттаивает, тем самым разрушая эти субстанции образовывая в них микротрещины и расширяя существующие капилляры, поры и пустоты, что в итоге приводит к усилению давления воды и образованию больше влаги. Помимо влаги со временем, рост микротрещин и капилляров приводит к активным протечкам в подвале, что в итоге тоже влияет на образование плесени. - Конденсат: Избыток конденсата вызывает образование плесени вокруг окон, дверей, холодных труб, бетонных полов и стен. Когда эти поверхности холодные, а в доме или здание тепло, образуется конденсат. Области с конденсацией или вблизи неё являются основными областями для роста плесени. Отсутствие теплоизоляции с внешней стороны стен подвала может привести к конденсату, так как зимой в доме работает отопление, а снаружи холодно.
- Плохая вентиляция: Если в подвале частного дома или коммерческого здания плохая вентиляция и при этом есть чрезмерная влага, то это может привести к тому, что влажный застоявшийся воздух будет производить плесень в подвале. Влага попадает в воздух из пара, образующегося при приготовлении пищи, уборке и купании. Вентиляторы и вентиляция в вашем доме рассеивают влагу, чтобы предотвратить появление плесени. Однако, когда вентиляция не работает, плесень может расти.



